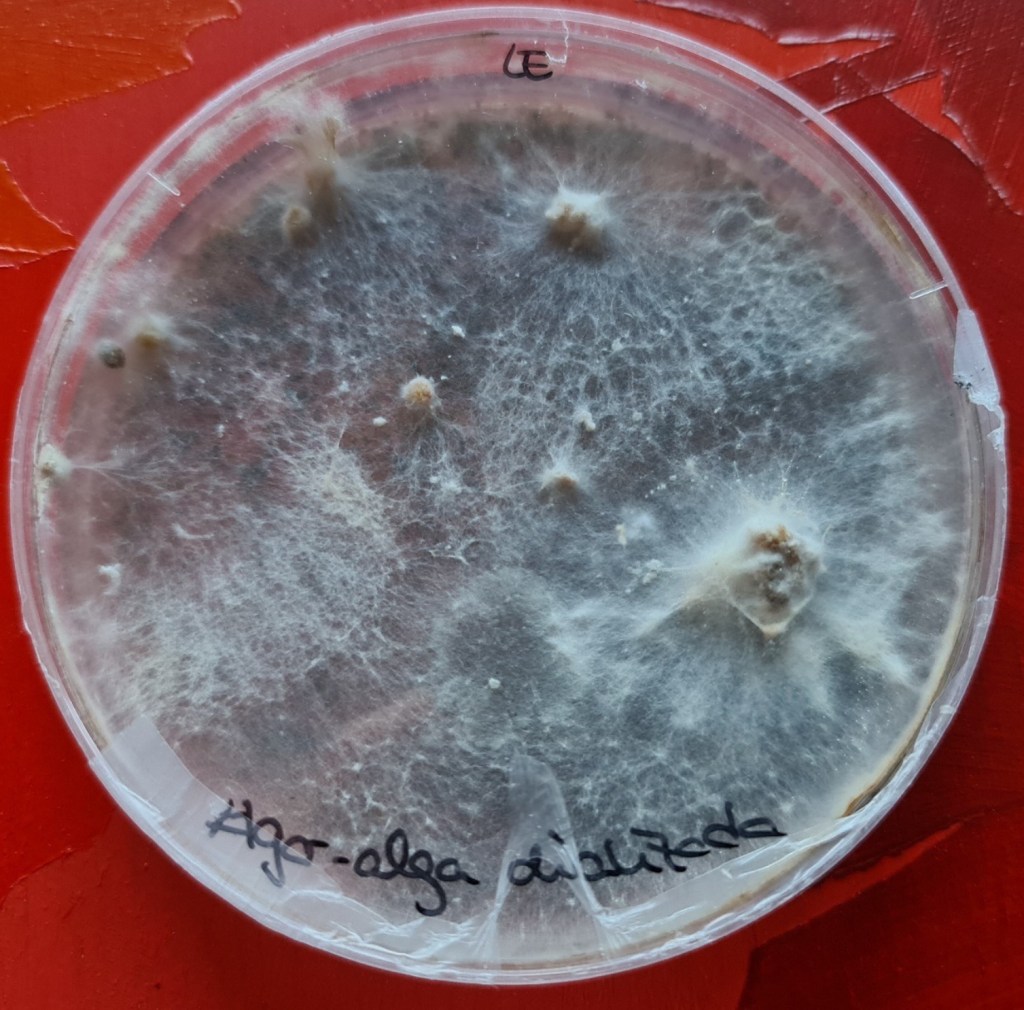
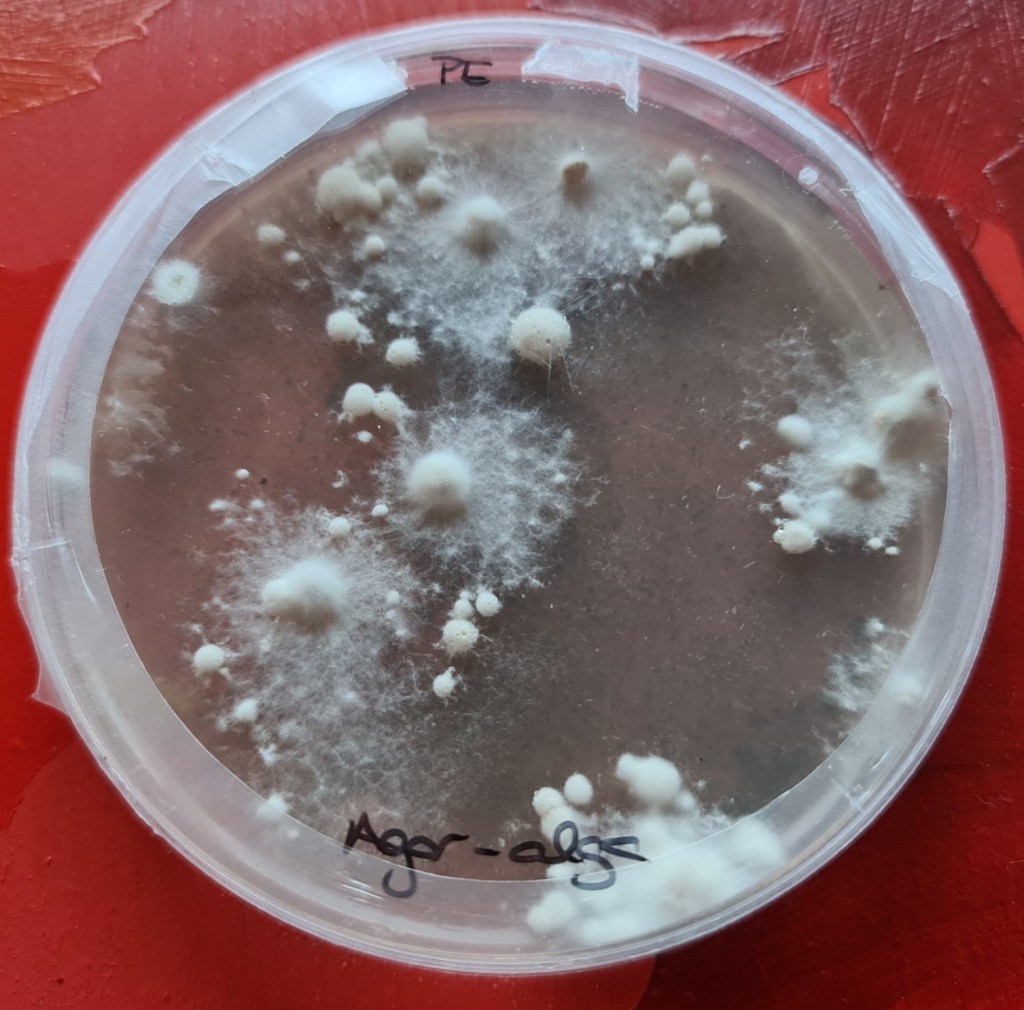

A finales del verano de 2021, Cristina Soler, profesora-investigadora de la Sección Departamental de Ciencias de la Alimentación de la UAM (y directora actual del Proyecto), tomó una muestra de algas degradadas en la orilla del Mar Menor y la inoculó con micelios de diferentes hongos comestibles (en escala de laboratorio).
La mitad de la muestra de algas se dializó (se le quitó la sal) en el laboratorio, la otra mitad se dejó tal cual. El micelio de algunos hongos comestibles no tuvo ningún problema en crecer sobre el residuo marino en una placa Petri, tampoco parecía retrasar su crecimiento el que el medio contuviera algas sin dializar.

Además, parecía que el medio que contenía algas del Mar Menor debía de tener algún compuesto especial porque se inducía la generación de primordios, que es el estado inicial de fructificación de las setas.


Tras estos resultados tan prometedores, se escribió la propuesta Algarikon. Fue financiada por los fondos TED y se está llevando a cabo desde diciembre de 2022 hasta noviembre del 2024.
Desde que empezó el proyecto hemos estado recogiendo algas de arribazones en diversas playas, estudiando las diferentes especies que constituyen las muestras tomadas en las cuatro estaciones y realizando análisis de sus composiciones. También tomamos varias muestras de una de las plantas de reciclaje donde se acumula la biomasa recolectada.
Al principio tomamos muestras en pequeñas cantidades para realizar pruebas iniciales en el laboratorio en pequeña escala, pero posteriormente necesitamos muchas más para realizar ensayos en plantas piloto.



Algunas de las muestras que tomamos las secábamos en la misma arena de la playa sobre una tela para simular su deterioro en la orilla de la laguna

Los arribazones de algas del Mar Menor estimulaban el crecimiento de las lechugas cuando se mezclan en cierta proporción con su sustrato ¿será por sus compuestos bioestimulantes?

De los arribazones de algas se pudieron obtener extractos que estimulaban la germinación y crecimiento de semillas de lechuga



El Servicio de Pesca y Acuicultura de la Comunidad Autónoma de la Región de Murcia, la Dirección General del Mar Menor y las empresas subcontratadas que trabajan recogiendo la biomasa de las orillas ayudaron en la recogida masiva. También los operarios de la planta de reciclaje de RECICLESAN nos facilitaron la tarea y nos dejaron un espacio para realizar pruebas y prepararlas para su transporte.

Posteriormente, las muestras frescas o secas, según el tipo de ensayo que se quería realizar, se enviaron a los centros de investigación participantes en el proyecto de Murcia, Madrid o La Rioja.
Una vez en los laboratorios o las instalaciones de cultivo, los investigadores del proyecto las procesan para probarlas como sustrato de cultivo para varias especies de hongos comestibles, como sustrato de lechugas o como materia prima para la extracción de compuestos de interés para la industria alimentaria o las empresas agronómicas.

Parte de los arribazones de algas recogidos se compostaron junto con otros materiales lignocelulósicos de zonas cercanas a la laguna del Mar Menor



También necesitamos recoger un poco del cieno anaeróbico que se acumula en los fondos del Mar Menor y probarlo como inoculo para realizar digestiones de las algas es decir, para evaluar su capacidad de producir biogás en biorreactores (metano) que pueda ser transformado en energía. Para ello, una parte del equipo del CIEMAT se desplazó en barco junto con buzos a una zona profunda para tomar muestras.
Tras probar varias mezclas y procedimientos conseguimos cultivar varias especies de setas comestibles en sustratos que contenían algas del Mar Menor con mayores rendimientos que los sustratos comerciales.



c


Los análisis realizados por una empresa externa indicaron que las setas crecidas en los arribazones de algas no tenían restos de ninguno de los plaguicidas mas frecuentemente usados en el campo de Cartagena (se analizaron un total de 621 compuestos por CG-MS/MS y LC-MS/MS) y sus niveles de nitratos y fosfatos eran los característicos de las setas.

A veces las condiciones para la toma de muestra no son las mas favorables, pero ahí estamos.

Algarikon ha crecido mucho!!! ya estamos realizando las pruebas en escala casi industrial y hemos podido producir muchos kilos de setas Pleurotus crecidas en algas del Mar Menor!



Para el desarrollo de Algarikon-zero volvimos a bucear para tomar muestras de lodos de diferentes zonas del fondo de la laguna


Con más dificultades para meternos pero, también conseguimos tomar muestras de lodos más superficiales, cercanos a las orillas del Mar Menor



